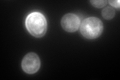

View description
Low affinity glucose transporter of the major facilitator superfamily, expression is induced in low or high glucose conditions
Localization:
Intensity:
Fold change:
Significance:
-
C’ GFP library in SD

cell periphery405.63 -
N' NOP1pr-GFP in SD

cell periphery98.2453 -
N' TEF2pr-mCherry in SD

cell periphery,vacuole175.102 -
N' NATIVEpr-GFP in SD

cell periphery177.293 -
N' TEF2pr-VC and Cyto-VN in SD

cell periphery,punctate44.0142 -
C’ GFP library in SD+DTT
cell periphery277.470.68No -
C’ GFP library in SD+H2O2

cell periphery323.680.79No -
C’ GFP library in Starvation Media

vacuoleN/AN/AYes -
C’ GFP library on the background of Pup2-DaMP

cytosol -
C’ GFP library on the background of CCT mutant

cell periphery347.9350.857747No
